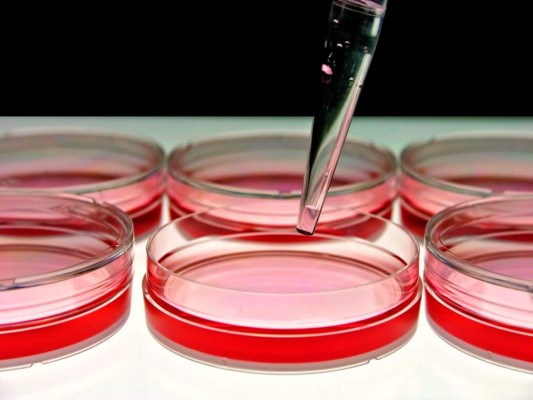
La terapia génica se posiciona contra cánceres de sangre y sistema inmune

Estados Unidos
La terapia genética, que corrige o sustituye genes mutados de una persona, se está posicionando como una de las vías para abordar algunos cánceres de la sangre, enfermedades hereditarias y trastornos del sistema inmune.
Esta terapia experimental ha sido objeto de algunas de las investigaciones presentadas, en la primera jornada de la 57 reunión de la Sociedad Americana de Hematología (ASH, por sus siglas en inglés) que concentra en Orlando (Florida, Estados Unidos) a más de 20.000 especialistas en hematología.
Esta técnica genética ha experimentado notables progresos, explicó George Dayle del Boston Children's Hospital, al mejorar la eficacia y la seguridad a largo plazo ya que en las primeras investigaciones se producían importantes niveles de toxicidad y susceptibilidad de leucemia asociada al tratamiento.
Así, uno de los estudios que más interés ha despertado en la cita mundial de la hematología de Orlando, a pesar de ser resultados preliminares pero 'esperanzadores', es un ensayo por primera vez en humanos.
Participaron 11 pacientes con mieloma múltiple avanzado, y una media de siete tratamientos fallidos previos, y se ha conseguido la la remisión de la enfermedad en uno de ellos.
El mieloma es un cáncer de la médula ósea producido por una degeneración maligna del ADN de las células plasmáticas con mayor prevalencia en hombres alrededor de los 70 años y es prácticamente incurable.
En la fase I del ensayo se utilizó las propias células T inmunes de los pacientes modificadas genéticamente para expresar un anti-receptor para reconocer y destruir las células de mieloma y se combinó con quimioterapia.
De los tratados con las dosis más altas: uno logró una remisión completa estricta dos meses después de la infusión de células T y el otro tuvo mieloma indetectable en las células plasmáticas de la médula ósea, pero aún no ha alcanzado un estado de remisión completa.
Como efectos secundarios, que lograron revertir, sufrieron síndrome de liberación de citoquinas, que se caracteriza por fiebre alta, dolor muscular y problemas cardíacos y renales.
El resto de los pacientes, tratados con dosis menores, experimentaron una mejoraría en la enfermedad o se mantuvieron estables con toxicidad y efectos secundarios leves, explicó James N. Kochenderfer, del Centro de Investigación del Cáncer.
Otros dos estudios presentados en ASH demuestran la promesa de la terapia génica utilizando un vector lentiviral para reconstruir los sistemas inmunes de los pacientes que sufren de dos enfermedades raras de la sangre, síndrome de Wiskott-Aldrich y la conocida como 'enfermedad del niño de la burbuja'.
El síndrome de Wiskott-Aldrich se caracteriza por bajos niveles de plaquetas, infecciones recurrentes, fácil aparición de moretones, sangrado, eczema, trastornos autoinmunes, y la alta susceptibilidad al cáncer. La enfermedad es causada por una mutación en el gen WAS.
Por su parte, la conocida 'enfermedad del niño de la burbuja' afecta casi exclusivamente a varones y está causada por mutaciones en el gen IL2RG. Estos niños nacen con fallos en el sistema inmune que les provoca infecciones que amenazan la vida.
Por otra parte, la reunión de Orlando ha analizado estudios que plantean nuevos puntos de vista sobre las mutaciones genéticas en los niños con leucemia linfocítica aguda (LLA) que indican un mayor riesgo de daño óseo asociada a la quimioterapia debilitante.
La terapia genética, que corrige o sustituye genes mutados de una persona, se está posicionando como una de las vías para abordar algunos cánceres de la sangre, enfermedades hereditarias y trastornos del sistema inmune.
Esta terapia experimental ha sido objeto de algunas de las investigaciones presentadas, en la primera jornada de la 57 reunión de la Sociedad Americana de Hematología (ASH, por sus siglas en inglés) que concentra en Orlando (Florida, Estados Unidos) a más de 20.000 especialistas en hematología.
Esta técnica genética ha experimentado notables progresos, explicó George Dayle del Boston Children's Hospital, al mejorar la eficacia y la seguridad a largo plazo ya que en las primeras investigaciones se producían importantes niveles de toxicidad y susceptibilidad de leucemia asociada al tratamiento.
Así, uno de los estudios que más interés ha despertado en la cita mundial de la hematología de Orlando, a pesar de ser resultados preliminares pero 'esperanzadores', es un ensayo por primera vez en humanos.
Participaron 11 pacientes con mieloma múltiple avanzado, y una media de siete tratamientos fallidos previos, y se ha conseguido la la remisión de la enfermedad en uno de ellos.
El mieloma es un cáncer de la médula ósea producido por una degeneración maligna del ADN de las células plasmáticas con mayor prevalencia en hombres alrededor de los 70 años y es prácticamente incurable.
En la fase I del ensayo se utilizó las propias células T inmunes de los pacientes modificadas genéticamente para expresar un anti-receptor para reconocer y destruir las células de mieloma y se combinó con quimioterapia.
De los tratados con las dosis más altas: uno logró una remisión completa estricta dos meses después de la infusión de células T y el otro tuvo mieloma indetectable en las células plasmáticas de la médula ósea, pero aún no ha alcanzado un estado de remisión completa.
Como efectos secundarios, que lograron revertir, sufrieron síndrome de liberación de citoquinas, que se caracteriza por fiebre alta, dolor muscular y problemas cardíacos y renales.
El resto de los pacientes, tratados con dosis menores, experimentaron una mejoraría en la enfermedad o se mantuvieron estables con toxicidad y efectos secundarios leves, explicó James N. Kochenderfer, del Centro de Investigación del Cáncer.
Otros dos estudios presentados en ASH demuestran la promesa de la terapia génica utilizando un vector lentiviral para reconstruir los sistemas inmunes de los pacientes que sufren de dos enfermedades raras de la sangre, síndrome de Wiskott-Aldrich y la conocida como 'enfermedad del niño de la burbuja'.
El síndrome de Wiskott-Aldrich se caracteriza por bajos niveles de plaquetas, infecciones recurrentes, fácil aparición de moretones, sangrado, eczema, trastornos autoinmunes, y la alta susceptibilidad al cáncer. La enfermedad es causada por una mutación en el gen WAS.
Por su parte, la conocida 'enfermedad del niño de la burbuja' afecta casi exclusivamente a varones y está causada por mutaciones en el gen IL2RG. Estos niños nacen con fallos en el sistema inmune que les provoca infecciones que amenazan la vida.
Por otra parte, la reunión de Orlando ha analizado estudios que plantean nuevos puntos de vista sobre las mutaciones genéticas en los niños con leucemia linfocítica aguda (LLA) que indican un mayor riesgo de daño óseo asociada a la quimioterapia debilitante.